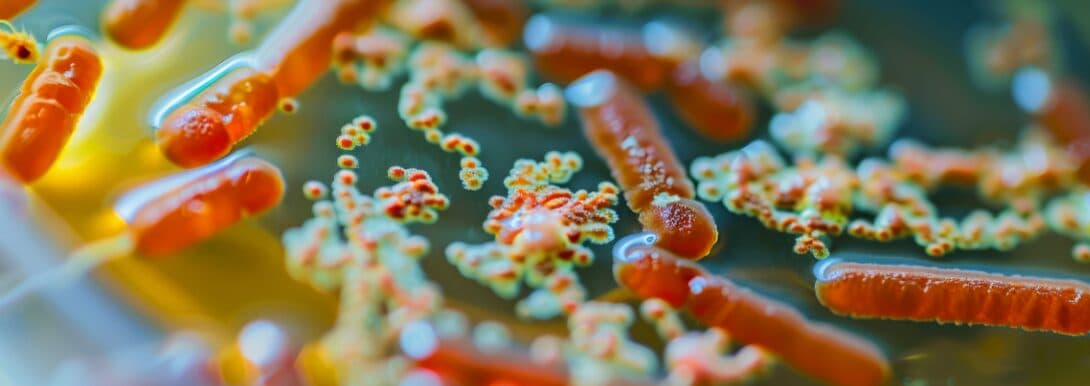
Sources and Types of Bioburden

Understanding and Controlling Bioburden: Definitions, Testing Procedures, and Best Practices

In the pharmaceutical industry, controlling bioburden is critical for ensuring product safety and compliance. Bioburden refers to the number of microorganisms present on a surface or in a substance, which, if not managed properly, can compromise product integrity and patient safety. This blog will provide an overview of bioburden, its sources, methods for testing, and best practices for controlling it.
What is Bioburden?
Bioburden refers to the population of viable microorganisms found on or within a product or material. It is commonly measured during the manufacturing process to assess the effectiveness of cleaning, sterilization, and handling procedures. The concept of bioburden differs from endotoxins, which are toxic substances released from bacteria after they die. While endotoxins can be harmful to human health, bioburden itself refers to live microbial contaminants that have the potential to reproduce and pose risks to pharmaceutical products.
The sources of bioburden are varied and can include raw materials, equipment surfaces, airborne particles, and even personnel. For instance, materials used in production can carry microbial contaminants from their origins. Similarly, manufacturing environments may contain microorganisms in the air or on surfaces if not properly controlled. Personnel, via skin particles, clothing, and respiratory droplets, can also introduce contaminants into clean areas, further complicating bioburden control.
How Can Bioburden Be Controlled?
Controlling bioburden requires a multifaceted approach that combines environmental management, stringent sanitation protocols, and continuous monitoring. Here are some key strategies:
- Environmental Controls: Pharmaceutical cleanrooms use advanced air filtration systems to minimize airborne contamination. Keeping a controlled environment is essential to preventing the spread of microorganisms.
- Sanitation Protocols: Regular cleaning of manufacturing equipment, tools, and surfaces helps reduce microbial buildup.
- Personnel Training: Proper training on hygiene and gowning procedures is essential to avoid contamination.
By implementing these strategies, manufacturers can effectively limit microbial contamination and ensure compliance with regulatory standards.

Sources and Types of Bioburden
Bioburden contamination can originate from a variety of sources within the pharmaceutical manufacturing process. These sources include:
- Raw Materials: Ingredients used in production may carry microorganisms, making it critical to test and treat these materials before use.
- Air and Water Systems: The manufacturing environment, including air quality and water systems, can be a source of microbial contamination.
- Human Contact: Personnel, despite following best practices, can inadvertently introduce bioburden through skin particles, clothing, and respiratory droplets.
The types of microorganisms that contribute to bioburden typically include bacteria, fungi, and mold. While bacterial contamination is the most common concern, fungi and mold can also become significant issues, especially in humid environments. Some manufacturing processes must also be cautious of viral contaminants, particularly in the production of biologics and vaccines, where sensitivity to contamination is even higher.
Bioburden Testing
Bioburden testing is one of the most critical steps in pharmaceutical manufacturing. It ensures that the level of microbial contamination is within acceptable limits. The bioburden testing procedure typically involves:
- Sample Collection: Samples are taken from various points in the production process, such as raw materials, surfaces, and water systems.
- Microbial Culture: The samples are incubated to allow microorganisms to grow.
- Quantification: After incubation, colonies are counted to determine the bioburden level.
Testing protocols follow guidelines from pharmacopeial standards like the United States Pharmacopeia (USP), which outlines the acceptable limits for microbial contamination in different pharmaceutical products. In some cases, more advanced methods like rapid microbial detection systems are used to speed up the testing process and improve response times.

Methods for Controlling Bioburden
There are several methods used to control bioburden in pharmaceutical manufacturing. The most common methods include:
- Filtration: Filters are used to remove microorganisms from liquids or air, ensuring a cleaner production environment.
- Sterilization: Techniques such as autoclaving, radiation, or the use of chemical agents like ethylene oxide are employed to kill microorganisms on equipment and surfaces.
- Disinfection: Regular cleaning with disinfectants helps maintain the cleanliness of surfaces and tools, keeping microbial contamination to a minimum.
Each method is selected based on the type of contamination risk and the specific needs of the manufacturing process.
Bioburden Control in Specific Industries
Bioburden control is critical across various industries, particularly in the pharmaceutical, medical device, and biologics sectors.
- Pharmaceutical Industry: Bioburden control is vital for ensuring that drugs remain free of microbial contamination. This is especially important in the production of sterile drugs, where any contamination can have serious consequences for patient safety.
- Medical Devices: Manufacturers of medical devices, such as surgical instruments and implants, must adhere to strict bioburden control standards to prevent contamination that could lead to infection during use.
- Biologics: Biologics, such as vaccines and cell therapies, are highly sensitive to contamination. Even small amounts of bioburden can compromise the safety and efficacy of these products, necessitating rigorous control throughout the production process.
Regulatory Requirements for Bioburden Control
Regulatory bodies such as the FDA and EMA impose strict guidelines for bioburden control in pharmaceutical production. These regulations ensure that manufacturers maintain clean and controlled environments to prevent contamination. Key standards include:
- USP Guidelines: The United States Pharmacopeia (USP) sets out detailed requirements for bioburden testing and acceptable limits for microbial contamination.
- ISO Standards: ISO 11737-1 outlines the methods for bioburden testing and sterilization of medical devices.
Adhering to these regulatory requirements is essential to maintaining product safety and avoiding costly recalls or regulatory action.
Advanced Techniques in Bioburden Control
As technology advances, new techniques are being developed to enhance bioburden control in pharmaceutical manufacturing. Some of these emerging techniques include:
- Rapid Microbial Detection Systems: Automated systems capable of detecting and quantifying microorganisms in real-time, allowing for faster testing and response times.
- Continuous Monitoring: Sensors that continuously monitor environmental factors, such as air quality and surface cleanliness, to detect contamination early.
- Nanotechnology: The use of antimicrobial nanomaterials on surfaces and equipment is being explored as a potential way to reduce microbial contamination in production environments.
These innovations offer promising new ways to manage bioburden and reduce the risk of contamination.
Best Practices
Implementing best practices is key to maintaining effective bioburden control. Some of the most important practices include:
- Regular Training: Ensuring all personnel are properly trained in hygiene and contamination prevention.
- Routine Audits: Conducting regular audits of the manufacturing environment and procedures to identify potential contamination risks.
- Cross-Contamination Prevention: Separating sterile and non-sterile production areas to minimize the risk of cross-contamination.
By following these best practices, manufacturers can minimize microbial contamination and ensure their products are safe for consumers.
In conclusion, controlling bioburden is a fundamental aspect of pharmaceutical manufacturing. Through proper testing, advanced control methods, and adherence to regulatory requirements, manufacturers can minimize contamination risks and ensure the safety of their products. Staying up to date with best practices and emerging technologies will allow the industry to continue improving its ability to control bioburden effectively.